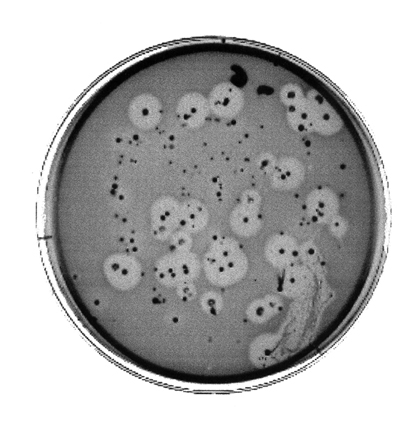

Sul ponte sventola bandiera bianca [scuola /3]
Comunque sia, adesso il pianeta è saturo. Ciò significa, fra l’altro, che i processi tipicamente moderni, come la costruzione di ordine e il progresso economico, si svolgono ovunque: quindi i “rifiuti umani” sono prodotti e sfornati ovunque in quantità sempre maggiori, ma stavolta in assenza di discariche “naturali” idonee al loro magazzinaggio e al loro potenziale riciclaggio.
Z. BAUMAN, Vite di scarto
Marginalizzazione dalla attività lavorativa?
In effetti sì.
Svuotamento delle mansioni?
Abbastanza, ma nemmeno rosso di sera… come si dice?
Mancata assegnazione dei compiti lavorativi con inattività forzata?
Sì, si può dire così…
Mancata assegnazione degli strumenti di lavoro?
Eh! Mica da oggi! Perdoni l’euforia…
Ripetuti trasferimenti ingiustificati?
Beh… ingiustificati… comunque sì, sì…
Prolungata attribuzione di compiti dequalificanti rispetto al profilo professionale posseduto?
Mi fa ridere sa dottore? Mi perdoni, Mi fa ridere e mi perdoni… ha mai compilato una domanda di immissione in una graduatoria per le supplenze scolastiche?
Impedimento sistematico e strutturale all’accesso a notizie?
Mi sta chiedendo se mi fido del sindacato?
Esclusione reiterata del lavoratore rispetto a iniziative formative, di riqualificazione e aggiornamento professionale?
Su questo in particolare avrei qualche parolina…
Dottoressa, mi dispiace, lei ha il mobbing…
È molto grave?
Prima di contrarre il mobbing non avevo mai avuto nemmeno un raffreddore. Non uno starnuto buono bianco e senza muco di quelli da far esclamare a uno sconosciuto in treno Salute signorina! tanto da prendermi sulle guance, come un buffetto nonno, la benevolenza e gli auguri del mondo. Niente, sono andata all’università sono rimasta all’università e adesso insegno a scuola. Il passaggio non è stato immediato però. Se il mobbing fosse una malattia a trasmissione sessuale io non l’avrei presa durante quegli anni perché studiavo troppo né devo averla contratta oggi perché il dottore continua a ripetere preoccupato che la malattia ha già fatto grossi danni ai canali lacrimali, alle nocche e all’amor proprio.
Il dottore sembra una brava persona e non si perde in metafore e infatti quando gli ho chiesto Dov’è l’amor proprio? mi ha domandato Da quanti giorni non ha un momento per pensare a sé?. Io dovrei avere quasi tutti i pomeriggi per pensare a me perché insegnare a scuola è un impiego a mezzo servizio con due mesi di ferie. Non è un contributo necessario alla formazione di una classe di donne e uomini pensanti e critici, non un divertimento, non un arricchimento e nemmeno un mestiere, no. È un impiego a mezzo servizio con due mesi di ferie pagate. Questo è quello che tutti sanno, che i giornali e la televisione raccontano, che mi rinfacciano talvolta gli studenti con genitori che sfoggiano arte e parte, e che tutto sommato, ma senza nessuna accezione saprofita o ansie classificatorie, è.
Se avessi contratto il mobbing in un’aula scolastica l’allarme avrebbe suonato più forte e coperto il trillo della campanella delle tredici e trenta. Perché io ascolto molto. Ma no, poi l’insegnamento è troppo recente per i danni che elenca il dottore e infatti ha supposto che io abbia contratto il mobbing in quel periodo al quale mi ero riferita con il passaggio non è stato immediato.
La scuola di specializzazione in didattica.
È pur vero che io ci sono arrivata in età da ripetente, perché avevo investito quattro anni in un dottorato di ricerca a tasso di interesse meno quattro virgola cinque, e la maggior parte dei colleghi da imberbi laureati, ma è altrettanto che quando si parla di studio e riflessione e insegnamento la curiosità, la trasversalità e la competenza dovrebbero essere addendi da mettere a fattor comune e a beneficio di tutti. Cosa che non è semplice in un posto dove sei costretto ad attestare la presenza con una firma e dove le firme false, per necessità o malavoglia, sono più importanti di quello che puoi imparare.
Se in parlamento ci sono i pianisti perché in altre aule dovrebbe essere diverso? Mi dica dottore!. Comunque, mi sono trovata a dover vivere nascostamente ogni nozione appena sopra la media. Anche qualche altro. E non per il solito malcelato, e a volte posticcio, understatement mi creda dottore!, Le credo, ora continui.
I docenti della scuola dei specializzazione sono quasi tutti professori universitari. Anche questo dovrebbe essere un valore e lo sarebbe se non vivessimo in una società nominalista. Che significa?, Che se io la chiamo dottore penso che lei possa curarmi, La ringrazio per la fiducia, Non è fiducia, è alfabetizzazione, sto leggendo sul suo badge, Oh!, è vero.
Il (pregio e il) difetto principale dell’università è quello di lavorare alacremente perché tutto rimanga esattamente com’è. E infatti solo un paio di docenti, in due anni di scuola, hanno rimodulato i corsi accademici su quelle che potevano essere le esigenze di una platea che l’indomani, non immediato, avrebbe insegnato a scuola. Entravano in classe e ripetevano le lezioni universitarie. I professori universitari non considerano l’insegnamento come un fenomeno da studiare in sé, affatto. Questo è quando andava bene. Quando andava male il tempo era perso in senso proprio, nemmeno nelle inani ripetizioni. Ma non voglio fare polemica, non so come avrei reagito io se fossi stata ex cathedra, so come ho reagito tra i banchi, cioè, il dottore lo sa. Mi ha detto che il mobbing è un batterio che vive gregario nelle sacche di coscienza di tutte le indoli versate all’interpretazione, come la mia, come una taenia, e che si sviluppa quando percepisce eccessiva diversità tra il sé e il mondo e divora i canali lacrimali, le nocche e l’amor proprio, come è successo a me. La diversità che io ho percepito durante quegli anni, che ora so di incubazione, riguardava la loro mancanza di curiosità intellettuale e il mio avercela in eccesso, il mio non capire che avrei dovuto sfoderare misericordia e il mio continuo accanirmi a far arrossire relatori e assistenti di laboratorio e colleghi furbi o solo intenti a preservarsi in una struttura oscura e più potente del singolo. Il dottore mi ha detto che la prima conseguenza dell’essere infettati dal mobbing è l’inibizione del concetto di Noi e la conseguente mancata secrezione linguistica del pronome.
Il Noi non esiste più, ci sono, sempre più presenti e contrapposti l’Io e il Loro. In decenni di aggregazione, anche di tipo banda armata come i settanta, in effetti c’era terrorismo politico ma non mobbing. Anche se spesso da quando l’ho contratto mi viene voglia di colpirne uno per educarne cento. Il dottore dice che è molto anomalo perché l’interpretazione è un fattore di sviluppo del mobbing almeno quanto è un vaccino per il terrorismo. O se non di colpirlo almeno di farlo saltare in aria. Il dottore dice che nonostante la nostra democrazia sia rappresentativa, il rappresentante del sistema non è il sistema. Mah. Che intrico. Io ho preso il mobbing quando loro, quelli che sapevano come me qualcosa più del luogo comune, hanno cominciato a dire Ma perché te la prendi così tanto?, Pensa alla salute!, Ma che ti frega che abbiamo pagato e dovrebbe essere una scuola professionalizzante?, Ma tu ci pensi che ce ne andiamo a lavorare?, È l’ultimo brandello di posto statale!, A me piace insegnare e lo farò a ogni costo e senza perderci la testa come te!. Io ho preso il mobbing quando le persone intelligenti che mi stavano intorno si sono vestite da stupide per andare avanti e la qualità s’è trasformata in sopravvivenza. E questo è tutto dottore mio.
[a latere] Insegnare stanca (chi segue)
DICOTOMIA: Divisione in due parti | (filos.) Divisione di un concetto in due concetti contrari che ne esauriscono l’estensione.
IL NUOVO ZINGARELLI, Vocabolario della Lingua Italiana
Se chi sa fa e chi non sa insegna… chi insegna a insegnare… che fa?
All’inizio di questo anno accademico e di questa nuova avventura nella scuola di specializzazione per l’insegnamento secondario mi divertivo appena snobisticamente a glossare il vecchio insulso detto. Stare tra i banchi a studiare e leggere è la seconda cosa che vorrei fare nella vita e me la tengo di solito ben stretta come un velocista che sappia di poter correre i cento metri in non più di undici secondi. Non un campione ma un buon diavolo da corsia otto. Così ascoltavo e glossavo, e ne ridevo con gli altri nella stessa barca. Anche se la barca non è mai la stessa. Prendevo appunti ligia come uno studentello imberbe che comunque beccheggia tra il curioso e lo sdegnato. Penna nera e matita. Ogni pomeriggio dalle quattro alle cinque ore intenta a corsi di area specialistica che quando è andata bene erano ripetizioni accurate di lezioni accademiche e solo in tre o quattro casi, cicli di interventi mirati a sviluppare curiosità e competenze nei discenti a uno e a due gradi di separazione. Io e la mia aula a venire insomma. La scuola di specializzazione si paga e cara, e le due sensazioni preponderanti, sibilanti tra i malumori e gli snack tampona-ansia, sono quelle di comprarsi l’accesso a un posto fisso malpagato e socialmente molto femminile e molto mal visto ma che comunque consente due mesi interi di ferie, e la sensazione di spreco. Le motivazioni per cui ci si iscrive non sono importanti perché l’obiettivo comune è lavorare.
Il Cincinnatus di Nabokov suggeriva che il senso dello spreco, la tragedia dello spreco, è il sintomo primo ed evidente del trovarsi in un regime di tirannide.
La scuola di specializzazione a Napoli, specialmente nei corsi di area comune- luogo comune (insegnamenti di pedagogia e varie), ti lascia addosso un senso di spreco che ha dell’immorale. Se categorie come morale ed etica ed estetica hanno ancora valore in un posto dove le cattedre di area comune capitano sotto le mani nervose di individui privi di qualsiasi spessore culturale e di qualsiasi attitudine all’interlocuzione e al dibattimento.
Qualunquismo e improvvisazione.
Ci sarà un bando ci saranno titoli ci saranno motivazioni. Ma c’è anche da ammettere Visti i soggetti figuriamoci il resto.
Scrivo questo senza astio, con molto senso della realtà e ancora senso di spreco. E appena di impotenza perché chiunque di essi, il più millantatore, potrebbe schermare la sua difesa con un Lei non sa di cosa sto parlando come può discriminare su contenuti che non appartengono al suo cursus studiorum. La platea alla quale questi loschi figuri si rivolge è fatta di persone laureate in discipline scientifiche, il linguaggio con cui qualcuno di essi si rivolge è offensivo e costituito da non più di cinquecento parole con la scusa Altrimenti non capite. Supporre la stupidità e l’ottundimento linguistico nell’interlocutore è pericoloso e molto gramo. Io mi sono iscritta perché mi piace insegnare, non che sia significativo o lodevole ma è la terza cosa che vorrei fare nella vita e spesso mi ci aggrappo con la pervicacia borghese piccola piccola di voler contribuire con qualcosa di produttivo per me stessa e per gli altri intorno.
A scuola non c’è posto sulla cattedra ma tra i banchi pare di sì. In uno di questi corsi, il giorno della registrazione dell’esame, il professore mi ha detto Le ho messo ventisei perché ha grossi problemi con la grammatica.
Io ho sorriso incredula e forse supponente all’uomo che pochi secondi prima aveva detto Dicotomia significa contraddizione.
[Questo racconto è stato scritto per Fare Libri, Laboratorio di tecniche]
I commenti a questo post sono chiusi

Resistere, resistere, resistere: ammaina bandiera bianca e mettine su una rossa, sembra più adatta…
tu dici che ce la facciamo a issare bandiera rossa?
:-)
chi
come al lido del sole a Scauri, chiara, quella da mare mosso e bacini a iosa
effeffe
Qualche giorno fa ho fatto un test. C’erano delle domande, c’erano tabelle con dati, e tu dovevi calcolare le varie risposte e cose così. C’era anche un esempio, per far capire come si doveva rispondere. La domanda chiedeva di dire a quale età, presumibilmente, un bambino che oggi ha tot anni, potrebbe arrivare. Ma la risposta giusta era dire quanti anni, presumibilmente, mancavano perché arrivasse a quella età. Nella definizione di dicotomia trovi “due concetti contrari”=contraddizione. Se un concetto si può dividere in due concetti contrari, eh. Suvvia. L’importante è essere su FB.
ehm. ho sbagliato. la risposta giusta era dire quanti anni ancora il bimbo si poteva aspettare di vivere. ma a parte questo.
ci sarà qualcuno, interno alla scuola, che dice che le cose vanno bene? che la riforma è una buona riforma? che gli studenti sono in gamba e gli insegnanti motivati?
perché siamo così incapaci di farci ascoltare?
perché una frangia di sindacato fa sembrare che senza posto fisso non si va a scuola. quando tutti ci andiamo senza posto fisso, comunque. e perché nessuno vuole sinceramente l’introduzione di un criterio meritocratico cheb forse porterebbe pure a una trafila più razionale per la selezione dei docenti. forse. insomma, me lo chiedo spesso.
chi
C’è una frase nel post di Chiara Valerio che mi pare significativa: «Io ho preso il mobbing quando le persone intelligenti che mi stavano intorno si sono vestite da stupide per andare avanti e la qualità s’è trasformata in sopravvivenza».
Gli allenatori di cavalli da corsa sanno che il problema più grosso non è far correre veloce l’animale bensì convincerlo che non c’è pericolo a farlo, che c’è un senso nell’arrivare davanti a tutti. L’istinto del cavallo, infatti, è sì correre ma in branco. Se stai nella pancia del branco per i predatori è molto più difficile puntarti. A essere in pericolo sono coloro che rimangono indietro, i più lenti e goffi, ma anche quelli che stanno ai lati, e perfino quelli più veloci e splendidi capaci di correre in avanti. Quelli veloci e splendidi sono i primi a incontrare i predatori, se questi tendono agguati, e sono anche coloro che rischiano di prendere direzioni diverse rispetto al resto del branco, rimanendo isolati quando il branco dovesse decidere di svoltare… e così con tutta la loro bellezza ed efficacia, si mettono in potenziale pericolo.
Ma noi siamo esseri umani, no? Noi sappiamo che chi spinge in là i confini del possibile è ricoperto di gloria e onore… no? Noi non siamo un branco di cavalli impauriti…
Guido Tedoldi
è bella l’immagine dei cavalli impauriti Guido. i cavalli sono forti, sono, belli, sono lucidi. dobbiamo smetterla di camminare con le briglie in ogni dove. grazie ;-)
chi
Ciao Chiara, sono molto belli questi tuoi pezzi sulla scuola, avrei voluto commentare anche l’altro sulla studentessa che “doveva dire la sua” ma non ho fatto in tempo (lì c’era il grande malinteso dello “studente al centro della didattica”, come se la didattica fosse il palcoscenico di maria de filippi).
Io sono stata in ssis per tre anni, come docente contrattista, avevo in realtà un gran desiderio di fare l’esame d’ingresso e provare a mettermi lì in graduatoria, per avere almeno “l’impressione” di stare costruendo qualcosa (quella cosa che citi tu “ma ci pensi, andiamo a lavorare!” – il preside per dissuadermi mi disse “non mi faccia fare figuracce”…mah).
La ssis mi pareva un gran distributore di scatole vuote. Il didattichese faceva un rumore assordante. Se provavo ad approfondire, a fare dei “bei discorsi culturali”, risultavo stucchevole: le studentesse dovevano barcamenarsi per coniugare le frequenze obbligatorie, i tirocini e la sopravvivenza. Se provavo a dare degli strumenti per insegnare sbattevo il muso contro le parche 20 ore del mio laboratorio di Lessicologia (notoriamente ‘utilissima’ nelle scuole superiori).
Ora la ssis ha chiuso i battenti, vediamo quale nuovo mostro le seguirà.
Io lavoro ancora a contratti semestrali (all’inizio avevo anche contratti a cottimo: pagata per numero di studenti esaminati), e avverto un gran senso di smobilitazione, di smantellamento.
Ecco, è solo una testimonianza, come vedi del tutto personale. Grazie per portare l’attenzione su questi temi.
un saluto caro,
r
ehi renata,
anche io lo scorso anno ho tenuto un corso alla SSIS. Storia delle idee Matematiche per l’indirizzo Tecnologico. Devo dire che è stata una esperienza molto bella perché gli specializzandi erano davvero preparati. e io stessa ho imparato molte cose. immagina una classe di persone provenienti da sostrati ed esperienze culturali e lavorative differentissime e in grado di creare lezioni trasversali e interattive. insomma, molto divertente.
comunque io penso che il punto sia cominciare a raccogliere testimonianze. di fatto. persone che fanno un lavoro, che hanno un mestiere, non angeli sterminatori e missionari come certe volt epure dobbiamo sembrare. e questo. grazie renata. :-)
chi
Questo pezzo per me è semplicemente strepitoso. Sei riuscita persino a farmi sghignazzare, lì, col dottore.
“cominciare a raccogliere testimonianze. di fatto. persone che fanno un lavoro, che hanno un mestiere”. Ottimo…
Adesso, scusami, ma mi hai fatto venire un desiderio: leggere una tua lezione sulla Dicotomia!
grazie precaria :-)
chi
sì, quel che dici giustamente mi fa venire in mente che non ho parlato del famoso “lato umano”: le ragazze erano fantastiche, chi con un paio di lauree, master all’estero e specializzazioni coi contro-fiocchi, o semplicemente belle persone appassionate. di rado ho incontrato qualcuno poco preparato e finito lì per caso. questi incontri mi hanno dato tanto come persona e come ricercatrice.
ed hai ragione anche sul testimoniare: bisogna continuare a parlarne e ad avvertire che se ce ne infischiamo tra qualche anno della scuola e dell’università non rimarrà che qualche brandello.
magari suoniamo troppo allarmiste e poi “ci sono ben altri problemi”? mi pare però che i brevi\lunghi anni di dissipazione della cosa chiamata “intelligenza” abbiano dato i risultati che vediamo (per esempio una classe politica tutta chiacchiere e distintivo).
un saluto caro,
r